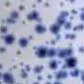

Utility Objects wholesale products
Utility Objects wholesale products
Utility Objects wholesale products
Find products for your store from thousands of brands.
Unlock wholesale pricingAbout Utility Objects
Based in Atlanta, Georgia, Utility Objects is a small batch ceramics studio by Afro-Latina ceramicist Aleisha Duchateau. Our pieces commonly feature satin to rock-like textures paired with earthy tones and pops of color. Drawing inspiration from Japanese philosophy of wabi-sabi to the playful splatterware techniques of 18th-century Europe. 𐃢𐃡 UO Ceramics Wholesale Policy Lead Time: 8–12 weeks from order confirmation. This is an estimation as delays are possible due to the handmade process; we communicate status updates regularly. No rush orders please--ceramics is a slow craft. Quality: 100% Food Safe. Crafted without lead or cadmium. Handmade: Expect and embrace natural speckles and slight variations—these are the essence of our one-of-a-kind artistry, not defects. Support: We reply within 48 hours. Damages and Returns/Cancellations (14 days max) must be processed exclusively through the Faire system.